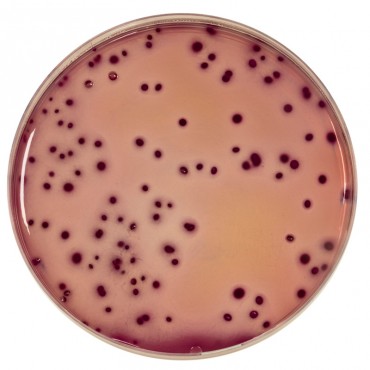

- +Products
- +Allergen testing
- +Culture Media - reagents and reference material
- +Environmental testing solutions
- +Laboratory Consumables
- +Laboratory equipment
- +Microbiology equipment
- +Neogen® Food Safety Solutions
- +Temperature & Humidity Monitoring
- +Services
- SUPPORT
- News
- +About Us
- Contact






VRBG Agar
Violet Red Bile Glucose Agar containing crystal violet and neutral red (VRBG Agar) was used by Mossel for the detection and enumeration of enterobacteria in dairy products, meat, prepared pork products and other food products.
The typical composition corresponds to that defined in the standards NF EN ISO 21528-1, NF EN ISO 21528-2 and NF V08-054.
Available as dehydrated medium : 500 g bottle or 5 kg drum
Ready-to-melt medium : 10 vials of 200 ml (BM07508)
In compliance with regulatory requirements, a USDA permit (VS 16-3) is mandatory for shipments from Canada to the USA due to the inclusion of peptone, an animal byproduct.
The simultaneous presence of crystal violet and bile salts inhibit Gram-positive bacteria.
The degradation of glucose to acid is shown by the red color of the pH indicator, neutral red
Download
Related Products